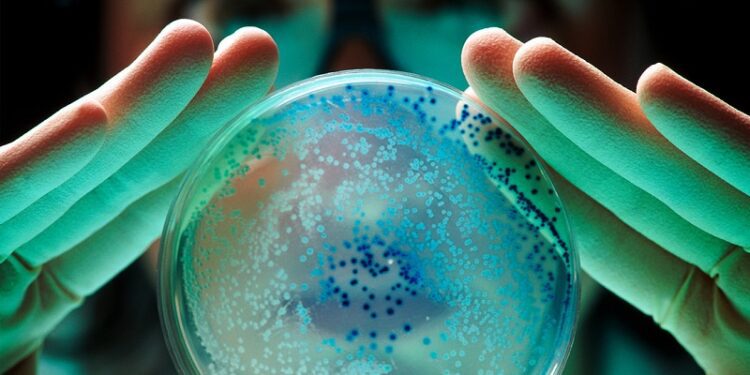
«Es como un fantasma»: un gen que hace invencibles a las bacterias se propaga por todo el mundo

Redacción (RT.com).-Un grupo de científicos ha alertado sobre un gen llamado ‘npmA2’, que dota a bacterias peligrosas de una resistencia total a los aminoglucósidos, un grupo de antibióticos vitales, y se está propagando por todo el mundo, según un artículo publicado este jueves en la revista Nature Communications.
Los investigadores, que analizaron casi 2 millones de muestras bacterianas, confirman que este gen actúa como un «pasaporte genético» que viaja en un fragmento móvil —cual «caballo de Troya»— y se incrusta en distintas bacterias, desde ‘Clostridioides difficile’, que causa infecciones intestinales, hasta ‘Enterococcus faecium’, responsable de contagios hospitalarios.
«El ‘npmA2’ es como un fantasma: casi nadie sabía de su existencia y, sin hacer ruido, ha empezado a aparecer en distintas partes del mundo y en bacterias que ya son difíciles de controlar», explicó Bruno González-Zorn, catedrático del Departamento de Sanidad Animal de la Universidad Complutense de Madrid (España) y autor principal del estudio.
Por su parte, el doctor Carlos Serna, que también participó en la investigación, señaló que el mencionado gen, que ha sido detectado en cepas de seis países y en muestras humanas, animales y ambientales, convierte ciertas infecciones en «prácticamente incurables».
https://actualidad.rt.com/actualidad/558078-gen-hacer-invencibles-bacterias-propagarse-mundo